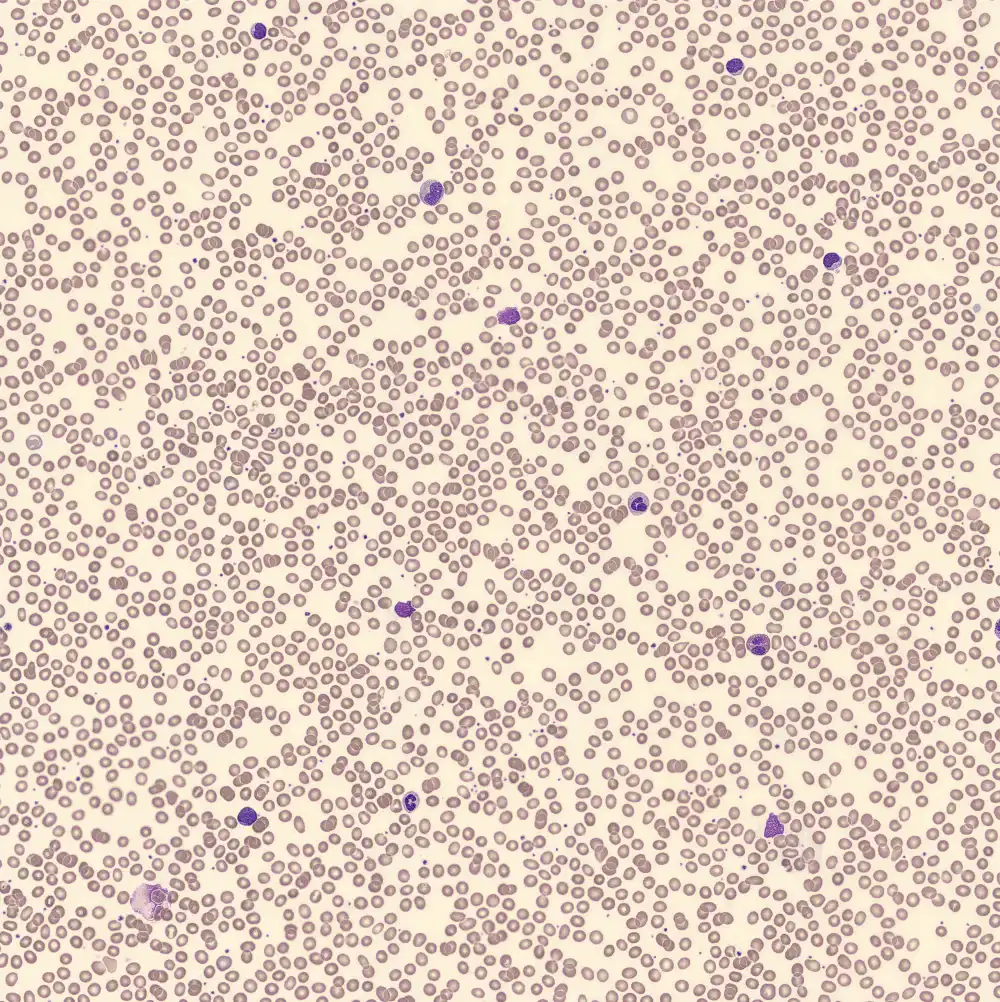

T-LGLL - Slide 2
Neutrophils
Lymphocytes
Monocytes
Eosinophils
Basophils
XN Scatterplots
Immunophenotype
CD3±
CD4-
CD8+
CD2+
CD7+
CD5±
CD57±
CD56-
CD16±
CD52±
TCRBC1±
TCRVb13.2+
Peripheral blood
Lymphocytes


















































































































































































































































